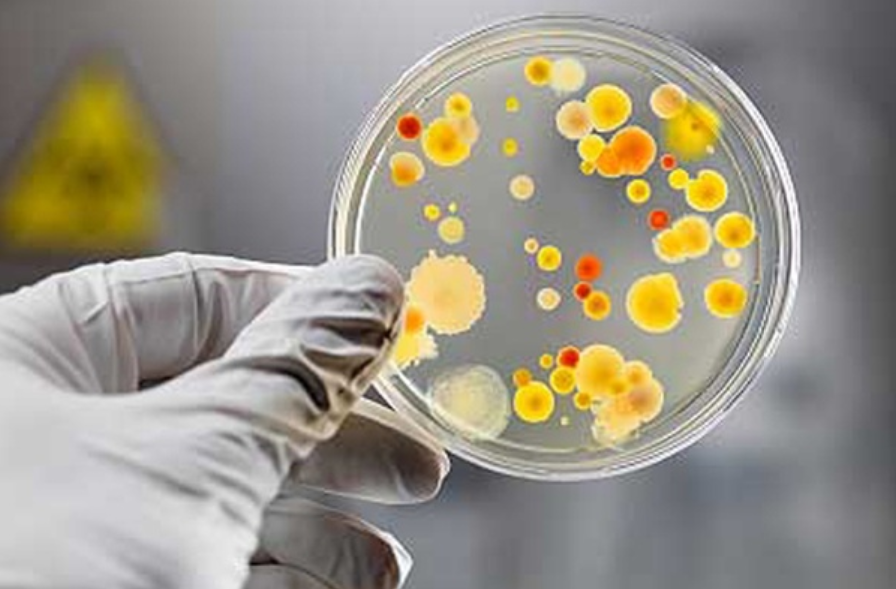

Fill 100,000 petri dishes a day!
They are used and discarded by scientists everyday. They are omnipresent in a lab, they are disposable, and are often disregarded. They are, the one and only, petri dishes. These well-known shallow and lidded plastic plates have been used to grow bacterial cultures and microorganisms for many years, serving a variety of uses, such as testing the virulence of bacterial cultures or examining the efficacy of antibiotic drugs in development. It is important to ensure that the petri dish is not only clean, but also sterile. This helps prevent the contamination of the new culture.
The process of filling peri dishes
Petri dishes need to be filled to just cover the bottom. Typically, 90-100 mm dishes require 10-15 ml agar. Agar, is a jelly-like polymer made up of various sub-units of galactose and various species of red algae. When filling petri dishes, a sterile environment is of utmost importance. However, the risk of contaminating the agar medium if poured manually into petri dishes should not be underestimated. The dish must also be rotated to obtain even surface coverage. It must be covered immediately and let to stand until firm. Usually filling machines for petri dishes take up a large amount of space and offer slow speeds, which is inefficient when a high-volume output is required. They also traditionally consume a lot of energy which is neither very cost efficient nor environment friendly.
Overcoming the challenges
Pharmaceutical innovators are constantly trying to design solutions to increase efficiency while reducing your overall footprint. As mentioned earlier, due to the level of precision required during the petri dish filling process it can be slow and also typically quite energy consuming. An attempt to make this process sustainable and low in cost has led to a filling equipment that takes less power than your household vacuum cleaner! Find out more about the below high speed petri dish filling machine that fills 90 mm petri dishes at 12,000 units per hour while needing less than half the space of a traditional filling system.